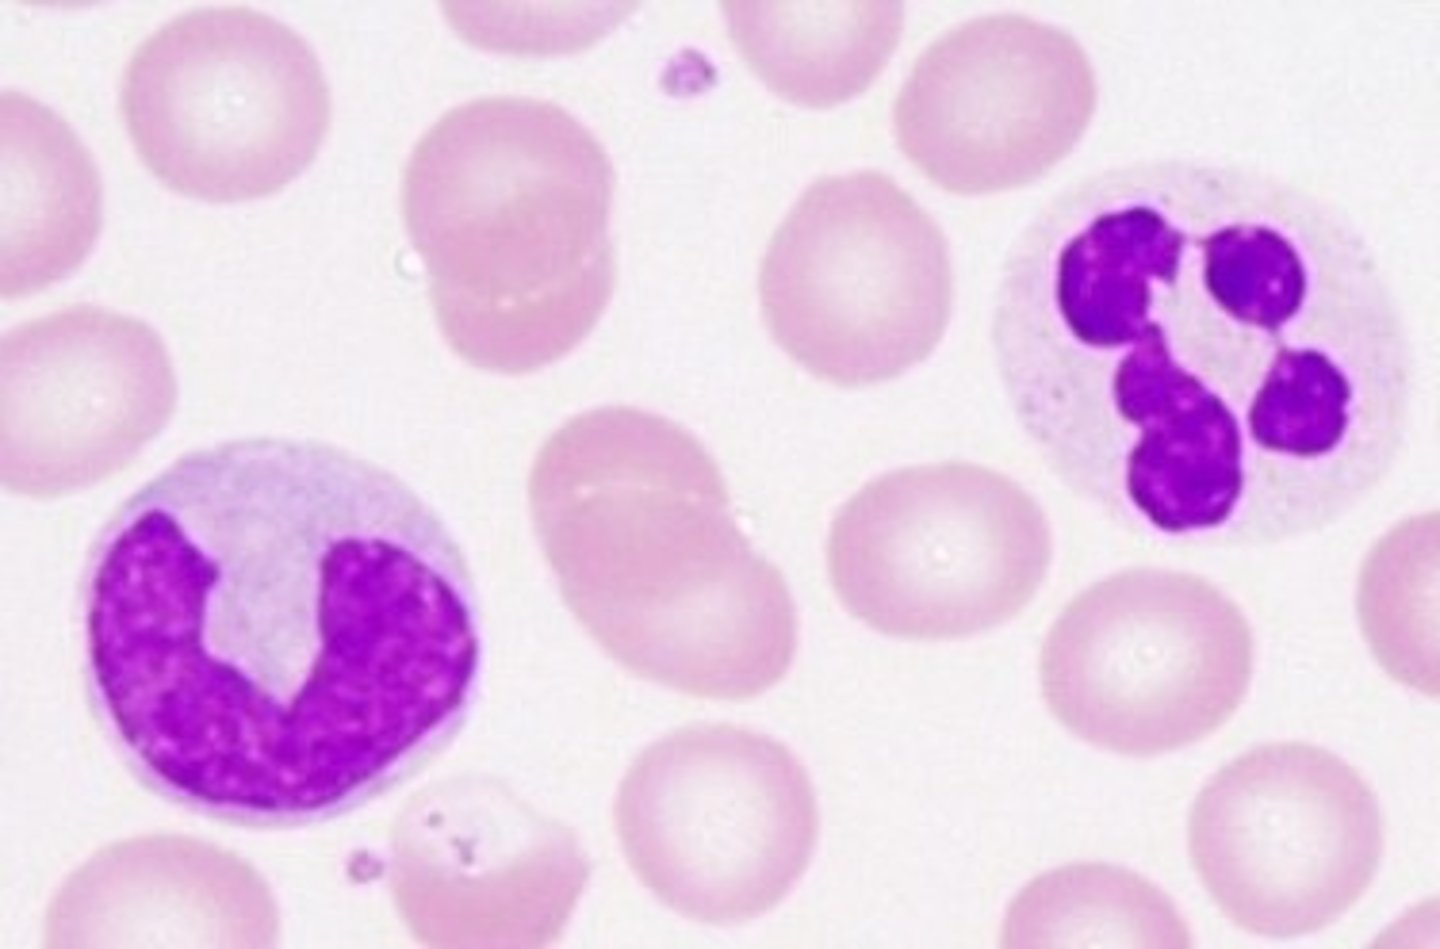
knowt flashcard image

Anatomy Lab Quiz 5 - Blood, Heart, and Blood Vessels
1/98
There's no tags or description
Looks like no tags are added yet.
Name | Mastery | Learn | Test | Matching | Spaced | Call with Kai |
|---|
No analytics yet
Send a link to your students to track their progress
99 Terms
red blood cells (erythrocytes)

white blood cells (leukocytes)
Platelets (thrombocytes)

Type A
1st line

Type B
2nd line

type AB
3rd line

type O
4th line

Rh positive

Rh negative

aortic arch

Ascending aorta

descending aorta

aortic semilunar valve

bicuspid (mitral) valve

pulmonic semilunar valve

tricuspid valve

Chordae tendineae

Papillary muscle

Cardiac vein

Coronary sinus

Left coronary artery

Circumflex artery

Left anterior descending artery

Opening to coronary arteries

Right coronary artery

Marginal artery

Posterior interventricular artery

Left pulmonary artery

Pulmonary trunk

Right pulmonary veins

Left pulmonary veins

Right pulmonary artery

Inferior vena cava

Superior vena cava

Auricle

Interatrial septum

Interventricular septum

Left atrium

Right atrium

Apex of heart

Base of heart

Ligamentum arteriosum

Left ventricle

Right ventricle

right coronary arteries

left coronary arteries

brachiocephalic trunk

left common carotid

left subclavian

left vertebral

external carotid

internal carotid artery

right common carotid

right subclavian

right vertebral

superficial temporal artery

facial artery

axillary artery

brachial artery

ulnar artery

radial artery

deep palmar arch

celiac trunk artery

superior mesenteric artery

renal artery

inferior mesenteric artery

internal iliac artery

external iliac artery

femoral artery

deep femoral artery

popliteal artery

anterior tibial artery

posterior tibial artery

dorsalis pedis artery

internal jugular vein

external jugular vein

brachiocephalic vein

subclavian vein

azygos vein

superior vena cava

brachial vein

axillary vein

cephalic vein

basilic vein

median cubital vein

internal iliac vein

external iliac vein

common iliac vein

renal vein

inferior mesenteric vein

superior mesenteric vein

splenic vein

hepatic portal

hepatic veins

Vena cava inferior

popliteal vein

femoral vein

deep femoral vein

great saphenous vein
